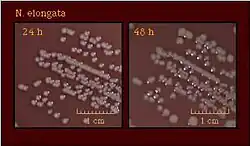

Neisseria elongata
| Systematyka | |
| Domena | |
|---|---|
| Typ | |
| Klasa |
betaproteobakterie |
| Rząd | |
| Rodzina | |
| Rodzaj | |
| Gatunek |
Neisseria elongata |
| Nazwa systematyczna | |
| Neisseria elongata Bovre & Holten, 1970 | |
Neisseria elongata – gatunek Gram-ujemnej bakterii o rzadko spotykanym wśród przedstawicieli Neisseria wydłużonym kształcie (pałeczka)[1]. Bakteria ta zasiedla ludzką nosogardziel[1].
Hodowla i morfologia
N. elongata tworzy szare kolonie o średnicy 1–1,5 mm po 20 godzinach hodowli na agarze z krwią, które nie wykazują aktywności hemolitycznej i najlepiej rosną w temperaturze 33–37 °C[1]. Bakteria ta, w przeciwieństwie do większości gatunków Neisseria, nie wytwarza katalazy[2]. Ponadto, nie jest zdolna do redukcji azotanów, ani do fermentacji węglowodanów takich jak glukoza, maltoza, sacharoza, laktoza, arabinoza, galaktoza czy ksyloza[1][2]. N. elongata jest również wrażliwa na dużą liczbę antybiotyków, m.in. kolistynę, penicylinę, streptomycynę czy erytromycynę[1][2].
Chorobotwórczość
Neisseria elongata jest uznawana za bakterię komensalną[3]. Odnotowano natomiast pojedyncze przypadki wywoływanych przez nią stanów patologicznych takich jak zapalenie wsierdzia czy zapalenie kości i szpiku[3].
Przypisy
- 1 2 3 4 5 K. Bovre, E. Holten, Neisseria elongata sp.nov., a rod-shaped member of the genus Neisseria. Re-evaluation of cell shape as a criterion in classification, „Journal of General Microbiology”, 60 (1), 1970, s. 67–75, DOI: 10.1099/00221287-60-1-67, ISSN 0022-1287, PMID: 5488467 [dostęp 2020-06-14].
- 1 2 3 Neisseria elongata - Gonorrhea - STD Information from CDC [online], www.cdc.gov, 11 stycznia 2019 [dostęp 2020-06-14] (ang.).
- 1 2 Guangyu Liu, Christoph M. Tang, Rachel M. Exley, Non-pathogenic Neisseria: members of an abundant, multi-habitat, diverse genus, „Microbiology”, 161 (7), 2015, DOI: 10.1099/mic.0.000086, ISSN 1350-0872 [dostęp 2020-06-14] (ang.).